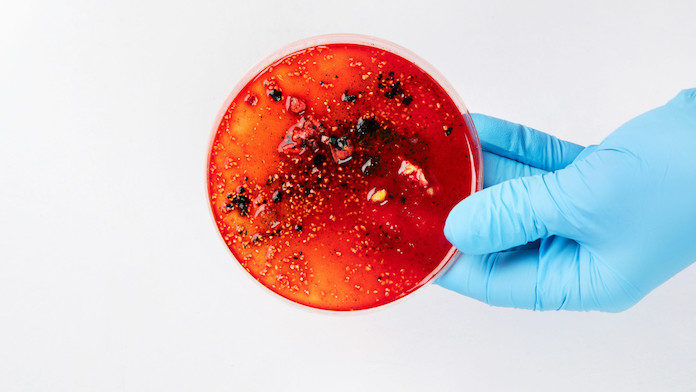
Sepsi: la sindrome invisibile che uccide 50.000 persone all’anno. L’intervista al prof. Antonelli

Sepsi: la sindrome invisibile che uccide 50.000 persone all’anno. L’intervista al prof. Antonelli
La sepsi non è una singola malattia, ma una sindrome complessa e potenzialmente letale. Si verifica quando la risposta immunitaria dell’organismo a un’infezione – che sia una polmonite, un’infezione addominale o urinaria – diventa così violenta da danneggiare i propri…